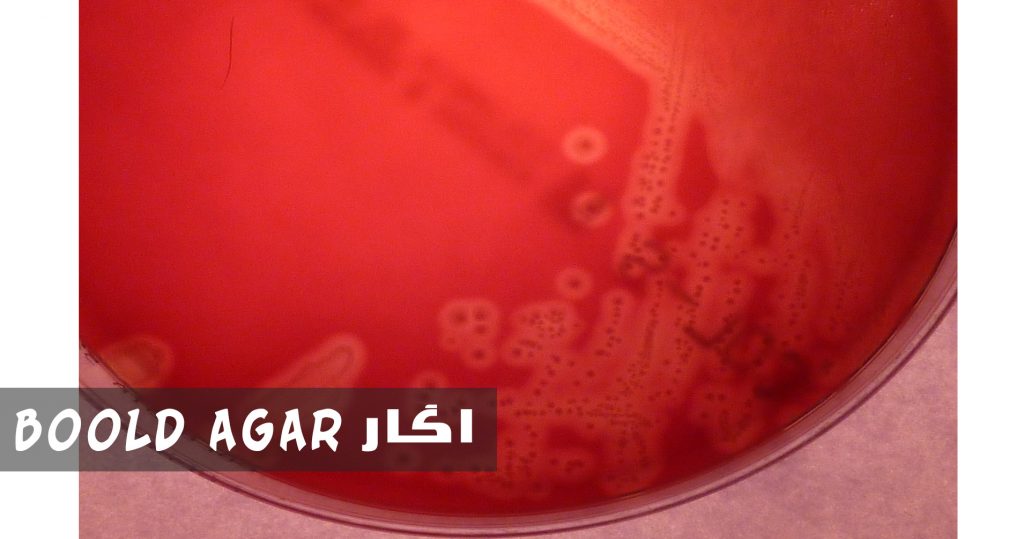
آگار خون آگار بولد بهترین آگارد
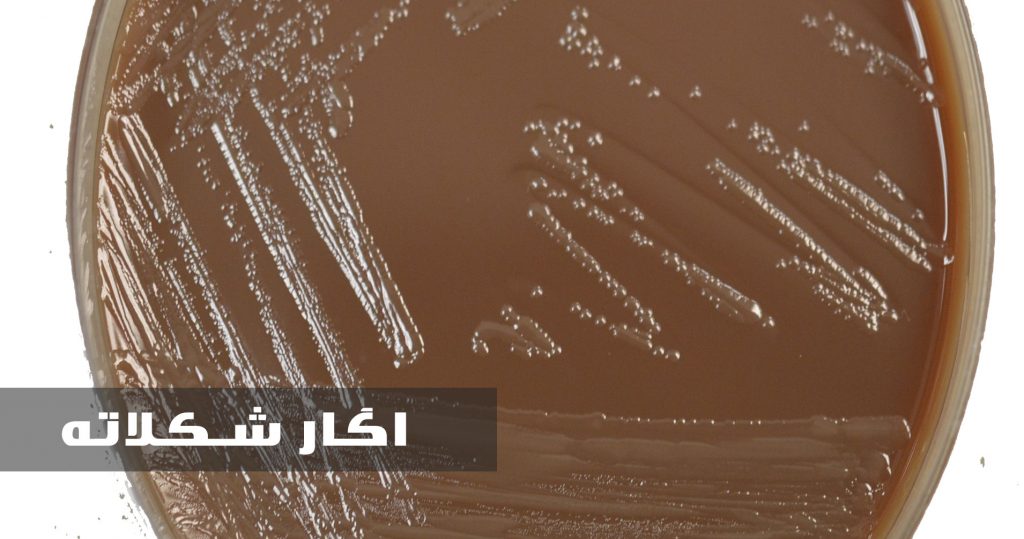
آگار شکلاته - شکلاته آگار

محیط کشت آگار | انواع محیط کشت اگار
محیط کشت آگار : محیط رشدی است که دارای اگار و به علاوه ی مواد مغذی می باشد و از آن برای کشت میکروارگانیسم ها یا گیاهان کوچک نظیر Physcomitrella patens استفاده می شود .
محیط کشت های دارای اگار به دو صورت جامد و نیمه جامد وجود دارد که درون پلیت یا لوله آزمایش تهیه می شوند.
انواع محیط کشت اگار
آگار خون دار (Blood agar)
یک محیط کشت غنی شده حاوی خون پستاندارانی نظیر اسب می باشد. این محیط کشت برای باکتری هایی است که به راحتی رشد نمی کنند و جداسازی این باکتری ها براساس خواص همولیتیک می باشد.
اکثر باکتری ها توانایی رشد در این محیط را دارند.
اگار شکلاته
زمانی که به محیط کشت اگار خون دار که در دمای بالا سلول های خونی بر اثر حرارت لیز می شوند و محتویات ازآن خارج می شود، خون دفیبرینه گاواضافه کنیم اگار شکلاته حاصل می شود.
این کشت درگونه های هموفیلوس و نایسریا مورد استفاده قرار می گیرد.
اگار شکلاته اطلاعات را همولیز نشان می دهد؛ بنابراین تمایز گونه ها درمیان اعضای هموفیلوس باید به روش دیگری انجام شود.

اگار Mac conkey
در این محیط کشت تنها باکتری های گرم منفی قادر به رشد می باشند و پودر اگار مک کانکی دارای دو نسخه است:
1ـ همراه با قند لاکتوز و
2ـ بدون قند اضافه شده
اگار میلر
آگار میلر یکی از اگارهای رایج می باشد که به نظر می رسد اجزای مشابه LB را فقط در ابعاد مختلف می تواند داشته باشد.
اگار غیر مغذی
این محیط کشت برای باکتری مناسب نیست و معمولاً برای رشد سایر میکروارگانیسم ها مورد استفاده قرار می گیرد .
اگار مغذی
دراین نوع اگار مواد مغذی می تواند گوشت گوساله و برخی از عصاره های مخمر باشد.
در اگار مغذی بزرگترین تعداد از انواع مختلف میکروب ها، قارچ ها و باکتری ها رشد می کنند ولی تمام انواع باکتری ها قادر به رشد در این محیط نیستند.

Endo agar
محیط کشت جامدی است از Endo agar که برای جداسازی نمونه های کلینیکی نظیر باسیل روده استفاده می شود.
سابور دکستروز آگار Saborad Dextrose agar
این محیط کشت به دلیل PH پایین و مواد غذایی اندک برای تکثیر قارچ ها مورد استفاده قرار می گیرد.
محیط کشت های دیگری مانند: ائوزین متیلن بلو آگار E.M.B، هكتون انتریک آگار، آگار سیترات بایل سالت سوکروز وجود دارد.
منبع این مقاله
چگونه می توان آگار را تهیه نمود؟
آگار- آگار را در تمام فروشگاه های آسیایی و هند پیدا خواهید کرد. پودر آن کمی گران تر از رشته ها یا پوسته ها است، اما همه آن ها کارایی خود را دارند.
برخی از خدمات سایت سفیر آزما کیان :
1- سیگما الدریچ | سیگما آلدریچ | نمایندگی سیگما الدریچ | نمایندگی سیگما الدریچ | خرید سیگما الدریچ
2- مرک آلمان | نمایندگی مرک | شرکت مرک آلمان | شرکت مرک
3- خرید کیت آزمایشگاهی و کیت آزمایشگاهی اورجینال و فروش مواد شیمیایی آزمایشگاهی
4- مشاوره پایان نامه و انجام پایان نامه در تمامی گرایش های پایان نامه








